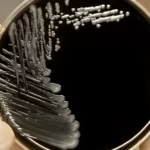

في مواجهة الأخبار والتداعيات الصادمة للتغيرات المناخية التي تعانيها غالبية دول العالم، هناك خبر سار، هو أنه يمكن تدريب جسم الإنسان على تحمل درجات الحرارة المرتفعة.

يتحدث خبير في التغير المناخي وطبيب متخصص في المناعة لموقع “سكاي نيوز عربية”، عن كيفية تحقيق ذلك، والتدريب الذي يحتاج إليه الإنسان ليعد جسمه لامتصاص الصدمات الحرارية غير المتوقعة.
تغيرات دائمة أم مؤقتة؟
لا يستبعد دوميط كامل رئيس حزب البيئة العالمي (جمعية مقرها بيروت هدفها التوعية البيئية)، أن التغير المناخي الذي يشهده العالم سيكون “دائما وليس مؤقتا”.
يستدل على ذلك بأن الاضطرابات المناخية “الخطيرة جدا” غيرت أحجام ومسارات الكتل الهوائية، وهو ما تسبب في ظهور “الاحترار العالمي” و”سيادة الطقس المتطرف”، ومع ارتفاع درجات الحرارة بشكل مستمر من المتوقع أن تصبح موجات الحر “أكثر تواترا وشدة، وانعكاساتها أوسع نطاقا بمرور الوقت”.
هل يمكن التكيف؟
الخبر السار أن هذا ممكن، ولو نسبيا، حسب كامل، الذي يضرب أمثلة:
بعض الكائنات الحية نجحت في تكييف نفسها مع ارتفاع درجات الحرارة، ويستطيع الإنسان بدوره أن يتكيف ويتعايش نسبيا.
حتى أولئك الذين لم يسبق لهم تجربة هذا النوع من الحرارة الشديدة من قبل، لديهم القدرة على التكيف لتحملها “بشكل أفضل”، لكن التعود على درجات الحرارة المرتفعة يستغرق وقتا، ولا ينبغي محاولة تحقيقه في وقت قصير، وتعريض الجسد عمدا لحرارة عالية ساعات طويلة.
التكيف والتأقلم ممكنان مع وجود مصدر مياه ومساحات زراعية خضراء في المكان، ومستحيل التأقلم في مناطق لا يوجد بها مياه أو زراعة، كذلك يمكن التكيف مع انخفاض شديد في الحرارة في مناطق شديدة البرودة لو توفر غطاء نباتي وزراعات تتماشى مع هذا الطقس.
التدريب التدريجي
ويقترح مستشار المركز المصري للحق في الدواء أخصائي المناعة محمد علي عز العرب، هذه الأمور ليدرب الإنسان نفسه على درجات حرارة أعلى مما اعتادها:
أن يعرّض الإنسان نفسه لنوبات قصيرة من الحرارة
والرطوبة، وزيادة مدة التعرض تدريجيا، وهي عملية تعرف باسم “التأقلم الحراري”.
هذا التعرض التدريجي المتكرر يمكن أن يؤدي إلى تكيفات فسيولوجية تحسن القدرة على تحمل درجات
الحرارة المرتفعة، وتساعد في تقليل خطر الإصابة بالأمراض المرتبطة بالحرارة.
هناك عضو بالمخ يساعد أجهزة الجسم على تحمل درجات الحرارة، ويخفف الشعور بالاحترار بإفراز العرق، مما يخفف الحرارة الخارجية.
لكن كل ما سبق يتم بحدود، ولا يكون مفيدا مع ارتفاع درجة الحرارة العالية جدا لأن هناك حدودا لقدرة الإنسان على التحمل، حيث يجب ألا تتجاوز 45 درجة مئوية.
من وسائل التكيف اتباع نظام غذائي نباتي وتقليل الاعتماد على المنتجات الحيوانية، لأن الأغذية النباتية تقلل الحاجة لشرب المياه وتساعد الجسد أكثر في تكييف نفسه.
تحسين اللياقة البدنية كذلك يساعد في تحمل الحرارة بشكل أفضل، لكن أن يكون ممارسة العمل الرياضي والبدني في حدود وبلا إسراف، حتى لا يصاب الإنسان بجفاف الجلد وضربات الشمس وأمراض قد تقود للوفاة.
التكيف مع درجات الحرارة يؤثر عليه كذلك عمر الإنسان وحالته الصحية والأدوية التي يتناولها.